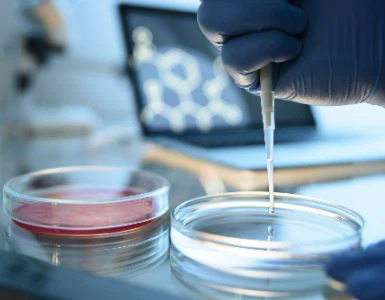
How Does NMN Alleviate Aging? How Does NMN Alleviate Aging?

How Does NMN Alleviate Aging?
Aging not only refers to the aging of the face, it is a natural phenomenon of human beings, with the passage of time, the gradual loss of physiological integrity, the impairment of bodily organ function, and various degrees of disability, which eventually leads to death.
Recent reports indicate that the use of Nicotinamide Mononucleotide (NMN) can delay aging and even make people look younger.

Japan was the first country to start studying NMN for human clinical use, and in some experimental animal models, NMN was shown to delay normal aging in animals.
Studies have shown that nicotinamide adenine dinucleotide (NAD+) levels are significantly reduced in multiple organs during aging, and the decline in NAD+ levels is a fundamental feature of aging;
SIRT1 is an NAD-dependent protein deacetylase, involved in the modulation of molecular clock components, and increased NAD+ content could increase the activity of SIRT1, thereby restoring the circadian rhythm system in aged mice.
Compared with the control group, NMN administration can effectively reduce the age-related physiological decline in mice, inhibit age-related weight gain, enhance energy metabolism, and promote Physical activity, improved insulin sensitivity and lipid profile, improved eye function and other pathophysiology;
and by assaying mouse platelets, blood chemistry panels, and urine cytotoxicity, NMN did not have any apparent toxic or detrimental effects, indicating that NMN has Safety;
and oral NMN is rapidly absorbed and converted to NAD+ in peripheral organs such as liver and skeletal muscle.
Given that NAD+ levels decline under conditions of aging or reduced health span, suggesting that reduced NAD+ levels may be a major cause of aging, supplementation with NMN can increase NAD+ levels, thereby delaying aging and preventing certain age-related disease.
*Special note - This article is for informational purposes only and cannot replace a doctor's treatment diagnosis and advice. It should not be regarded as a recommendation or proof of efficacy of the medical products involved. If it involves disease diagnosis, treatment, and rehabilitation, please be sure to go to a professional medical institution to seek professional advice.
by GSHWORLD
GSH Bio Tech is China Biological API Manufacturer. China NMN powder suppliers & best NMN raw material Factory.




